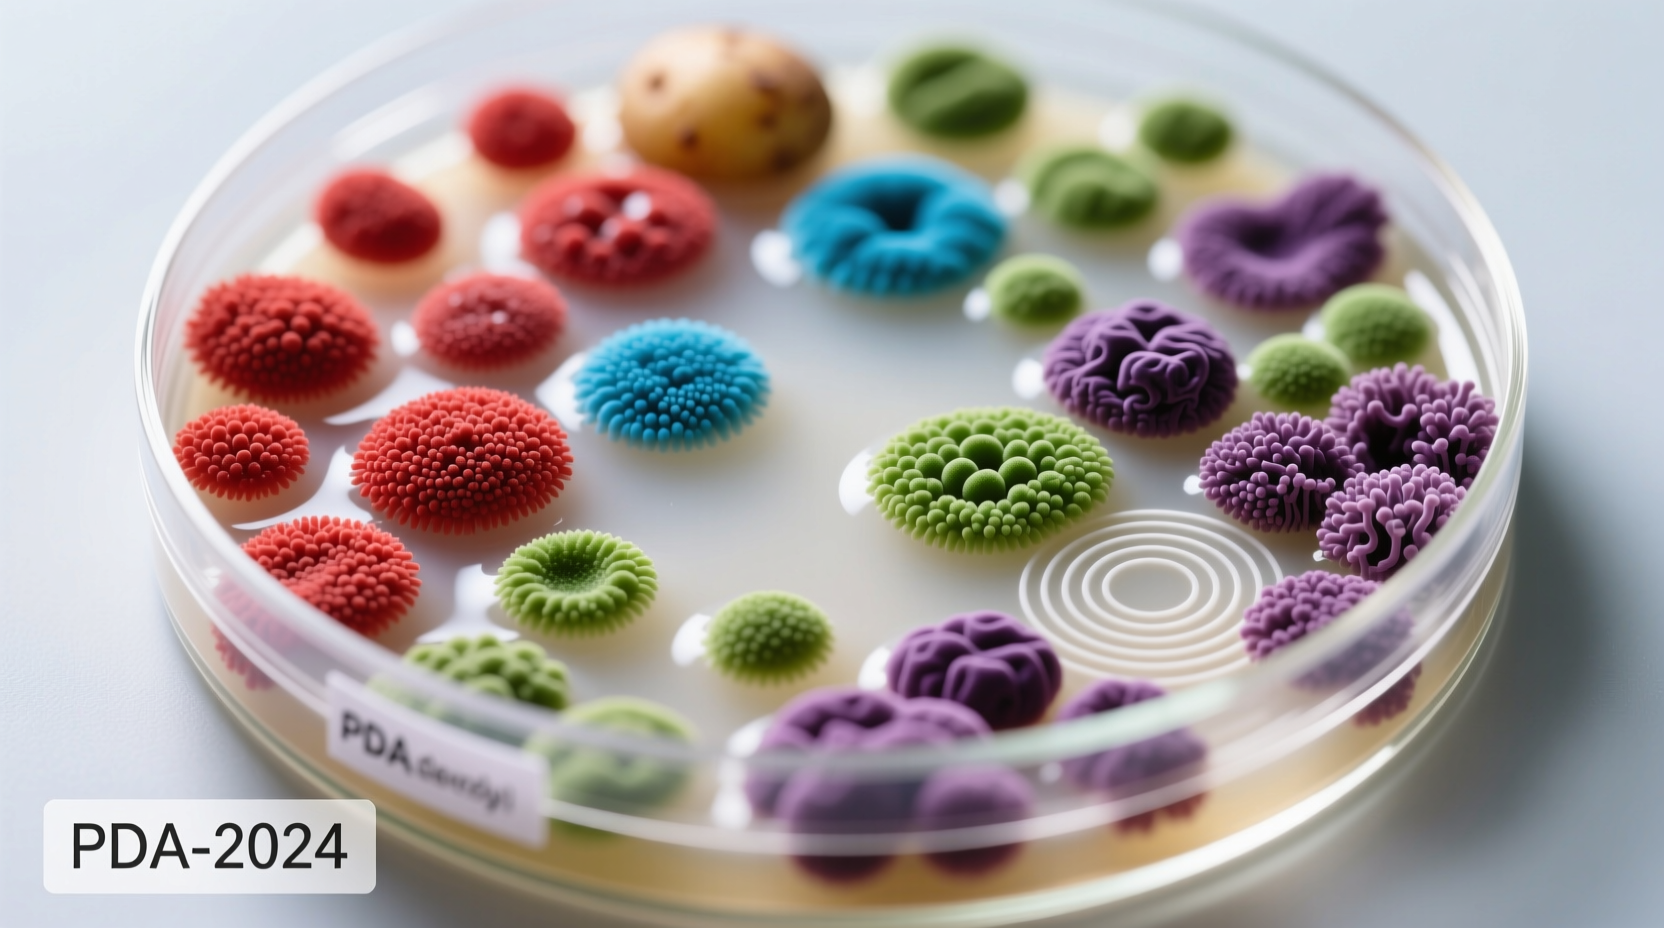
Microbial colonies growing on potato dextrose agar plate

Potato dextrose agar (PDA) is a nutrient-rich culture medium composed of potato infusion, dextrose (glucose), and agar, specifically designed for cultivating fungi and certain bacteria in laboratory environments. This versatile medium supports the growth of a wide range of microorganisms including yeasts, molds, and some bacterial species, making it indispensable for food safety testing, environmental monitoring, and clinical microbiology applications.
Discover exactly how potato dextrose agar works, when to use it, and why it remains the gold standard for fungal cultivation after decades of laboratory use. Whether you're preparing for a microbiology experiment, troubleshooting culture issues, or selecting the right medium for your specific application, this guide delivers the precise information you need to achieve reliable results.
What Is Potato Dextrose Agar and How Does It Work?
Potato dextrose agar provides the ideal nutritional environment for fungal growth through its simple yet effective composition. The potato infusion supplies essential vitamins, minerals, and nitrogen sources, while dextrose (glucose) serves as the primary carbon source that microorganisms metabolize for energy. The agar component creates a solid surface that allows for colony formation and isolation.
Unlike more specialized media, PDA's broad-spectrum formulation makes it particularly valuable for initial isolation of unknown fungi from environmental samples. Its slightly acidic pH (typically 5.6) creates conditions favorable for fungal growth while inhibiting many bacterial contaminants—a crucial advantage when working with mixed samples.
Step-by-Step Preparation Protocol
Preparing PDA correctly is essential for consistent results. Follow this verified laboratory protocol:
- Combine 200g peeled potatoes (boiled for 30 minutes) with 1 liter of distilled water
- Add 20g dextrose (glucose) and 15-20g agar powder to the potato infusion
- Adjust pH to 5.6 using dilute hydrochloric acid
- Sterilize by autoclaving at 121°C for 15 minutes
- Pour into sterile Petri dishes under laminar flow conditions
- Allow to solidify completely before use (approximately 30 minutes)
For commercial applications, pre-formulated PDA powder offers consistent results with reduced preparation time. Always include appropriate controls when using PDA for diagnostic or regulatory testing.
When to Choose PDA Over Alternative Media
Understanding the specific scenarios where PDA excels helps optimize your laboratory workflow. The following comparison highlights key decision points:
| Culture Medium | Best For | Limitations | Incubation Time |
|---|---|---|---|
| Potato Dextrose Agar | Fungi, yeasts, some bacteria | Limited bacterial differentiation | 2-7 days |
| Sabouraud Dextrose Agar | Dermatophytes, pathogenic fungi | Less effective for environmental fungi | 5-14 days |
| Nutrient Agar | Bacteria, limited fungi | Poor for fastidious organisms | 24-48 hours |
| MacConkey Agar | Gram-negative bacteria | Useless for fungi | 24-48 hours |
Evolution of PDA: From Kitchen Staple to Laboratory Standard
The development of potato dextrose agar reflects scientific ingenuity in adapting readily available materials for laboratory use:
- 1910s: Early microbiologists discovered potatoes provided excellent growth medium for fungi
- 1930s: Standardized formulations emerged with the addition of dextrose for consistent results
- 1950s: PDA became the preferred medium for food microbiology testing
- 1970s: Commercial production of dehydrated PDA simplified laboratory preparation
- Present Day: PDA remains the reference medium for fungal cultivation in ISO and FDA protocols
Practical Applications Across Scientific Fields
PDA's versatility makes it indispensable across multiple disciplines:
Food Safety Testing
Regulatory agencies including the FDA and EFSA specify PDA for detecting fungal contamination in food products. The medium's ability to support growth of spoilage organisms like Aspergillus and Penicillium species makes it essential for shelf-life determination and quality control.
Clinical Microbiology
While not the primary medium for pathogenic fungi identification, PDA serves as an excellent initial isolation medium for dermatophytes and other fungal pathogens. Its use is documented in the CDC's Laboratory Procedures Manual for certain fungal culture protocols.
Environmental Monitoring
Indoor air quality professionals rely on PDA for mold assessment. The medium's capacity to grow a wide range of environmental fungi helps identify potential contamination sources in buildings. According to the EPA's Mold Remediation Guidelines, PDA remains a recommended medium for viable mold sampling.
Limitations and When Not to Use PDA
Despite its versatility, PDA has specific limitations that affect its suitability for certain applications:
- Bacterial differentiation: PDA lacks selective agents for distinguishing between bacterial species
- Fastidious organisms: Some specialized fungi require additional nutrients not present in standard PDA
- pH sensitivity: The medium's natural acidity inhibits certain alkaliphilic microorganisms
- Overgrowth issues: Rapid-growing molds can overwhelm slower-growing species in mixed cultures
For bacterial work, consider nutrient agar or specialized media. When identifying specific fungal pathogens, supplement PDA with selective agents or use specialized media like Sabouraud dextrose agar.
Troubleshooting Common PDA Issues
Address these frequent challenges to ensure reliable results:
Contamination Problems
If your plates show unexpected bacterial growth, consider adding antibiotics like chloramphenicol (50 mg/L) to inhibit bacteria while allowing fungal growth. Always prepare media under sterile conditions and validate your sterilization process regularly.
Poor Growth or No Growth
Check agar concentration (should be 1.5-2.0%), verify pH (5.4-5.8 is optimal), and ensure proper incubation temperature (25-30°C for most fungi). Some fastidious organisms may require supplementation with yeast extract or other nutrients.
Excessive Moisture
Condensation on plate lids can interfere with colony observation. Allow plates to dry in a laminar flow hood for 15-30 minutes before inoculation, or store prepared plates at room temperature for 24 hours before use.
Safety and Storage Guidelines
Handle PDA with appropriate laboratory precautions:
- Always prepare and handle media in a certified biological safety cabinet
- Autoclave used plates before disposal to prevent environmental contamination
- Store prepared media at 2-8°C and use within 4 weeks for optimal results
- Label all plates with date, medium type, and any supplements added
- Follow institutional biosafety protocols when working with pathogenic organisms
Advanced Modifications for Specialized Applications
Researchers often modify standard PDA formulations to address specific needs:
- PDA with antibiotics: Add chloramphenicol (50 mg/L) to suppress bacterial growth
- Dichloran Rose Bengal PDA: Enhances separation of fungal colonies and inhibits spreading molds
- Acidified PDA: Lower pH to 3.5 for selective growth of yeasts over molds
- Supplemented PDA: Add 0.1% yeast extract for fastidious organisms
These modifications, documented in the ATCC Media Recipes database, demonstrate PDA's adaptability to diverse research requirements.











 浙公网安备
33010002000092号
浙公网安备
33010002000092号 浙B2-20120091-4
浙B2-20120091-4